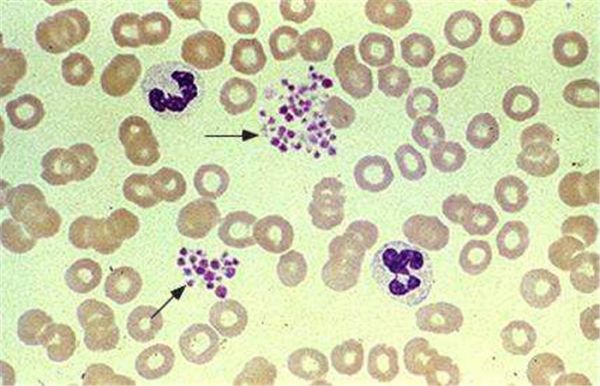
5轻度红细胞聚集
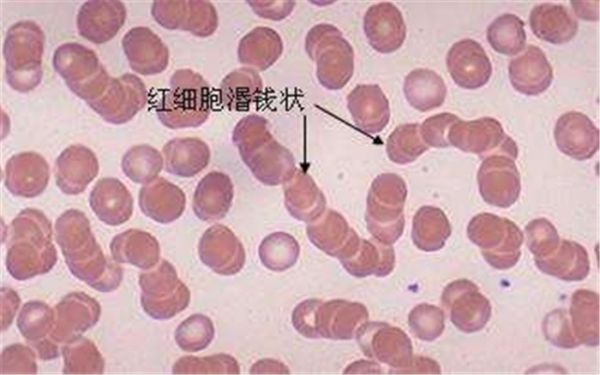
6中度红细胞聚集

导读:
近年来猝死事件频发,"心肌梗死"、"脑梗塞"年轻化的趋势越来越明显,"心梗"与"脑梗"越来越频繁地出现在生活中,而"凶手"就是大家常说的血栓!
一旦血栓形成,造成血管堵塞,堵在心脏形成心梗, 堵在脑部形成脑梗,心肌或脑组织就会相应地出现急性的缺氧、缺血和坏死。
两个"梗"根本原因是一样的,都是由于血栓堵塞血管导致的血液循环受阻。

接下来,让我们走进血液循环的微观世界,认识一下血液里的重要成员——红细胞。
专家告诉你红细胞的重要性
红细胞是血液中数量最多的细胞,在我们体内不断地循环流动,承担着运输营养物质与氧气,“浇灌”全身组织与器官的使命,清理体内自由基。
血液的健康质量很大程度上取决于红细胞的活性。
健康的红细胞是这样的

健康红细胞是一个个独立的个体,不成块、不成团、分散、游离,充满活力。在显微镜下可观察到:红细胞形态、大小正常,无多形性。

不健康的红细胞会造成什么影响?

由于不健康的生活方式,人体衰老等原因,会造成红细胞表面电荷分布异常,引起红细胞的聚集。
红细胞聚集的程度越大,相应的血液粘稠度就越高,越容易引发脑梗、心梗、冠心病等血栓类的疾病。
依据血红细胞的活性程度,不健康的红细胞可大致划分为以下3类:
1、轻度红细胞聚集
▲红细胞粘连
红细胞呈现粘连状,蛋白异常导致红细胞表面电荷失衡,引起红细胞成特殊状连接(一般为3-5个红细胞成串连接)。此时血粘度偏高,红细胞已经开始慢慢失去活力,若不及时纠正,则会发展为缗钱状排列。
【对应症状】
轻度的血液粘稠度通常不会有明显的不适感觉,但如果不加以注意,就会让血液粘稠度不断加重。
2、中度红细胞聚集
▲红细胞成缗 [mín] 钱状
红细胞缗钱状形成,表现为红细胞像钱币叠成一串。此时血液粘度较高,红细胞已基本失去活力,红细胞有效的表面积大量减少,导致氧气输送发生极大障碍。
【对应症状】
中度血粘稠的人往往会出现嗜睡、衰弱、乏力,早上醒来精神不佳,这是由于血流缓慢,易发生组织淤血和缺氧所导致。长期以往,身体机能会下降,伴随出现头昏、目眩、耳鸣、手脚麻木,冠状动脉供血不足,还可发生意识障碍等。
3、重度红细胞聚集

▲红细胞成团状
重度红细胞聚集会形成团块状,极易堵塞毛细血管。此时血液粘度很高,红细胞已完全失去活力,它不仅限制了氧气的自由交换,而且减少了通过毛细血管的血流量。若不采取治疗措施,则会形成大的血凝块。
【对应症状】
当人的血液长期处于高黏稠的状态,血液流速减慢会导致机体组织所需的氧气和营养物质长期供应不足,极易出现血液凝集块、造成血管栓塞。临床上有很多疾病,如动脉硬化、脑血栓、心肌梗死、高血压、糖尿病以及慢性肝肾疾病等都与血稠有着密切关系。
提早发现红细胞聚集至关重要
红细胞聚集是发现早期急性心梗的主要特征之一!
通过以上对红细胞微观的解读,我们知道改善红细胞的聚集状态对预防脑梗、心梗、冠心病等至关重要。所以,检测红细胞的聚集状态显得尤为重要!
检测:EIS红细胞影像系统

EIS红细胞影像系统:通过采集1微升指尖血,采用德国徕卡高分辨率显微镜,直观红细胞聚集状况和滚动变形能力,检测安全、快捷、直观。
非药物干预见效快
血液是生命活力的源泉,一旦我们的血液变得粘稠,血细胞渐渐失去了活性,随之而来的便是生命体的衰老与枯竭。采用非药物干预方式,尽快解决红细胞聚集问题,让血液健康起来,消除疾病隐患。
干预:ERS红细胞聚集康复系统

ERS红细胞聚集康复系统:采用仿生脉冲磁共振原理,修正红细胞膜表面的电荷异常分布,减少和消除红细胞聚集状态,预防因红细胞聚集引起的脑卒中、急性心肌梗死、冠心病、肺栓塞等血栓类疾病。
EIS红细胞影像系统+ERS红细胞聚集康复系统相结合的检测干预方式,形成了针对心梗等心血管疾病风险的功能检测和功能康复的闭环管理,对于因红细胞聚集引发的相关血栓类疾病的预防和干预意义重大。

一些三甲医院、体检中心、健康管理机构等应用EIS红细胞影像系统+ERS红细胞聚集康复系统相结合的方式,将为广大心脑血管疾病等慢性病的患者带去福音。相信,未来这两款设备将加快实现慢病的干预康复,更加有利于促进我国慢病管理、健康管理、医疗业务协同健康发展。更多详细信息请进入秦皇岛市惠斯安普医学系统股份有限公司》》


找产品
招代理商
找工作
查数据




